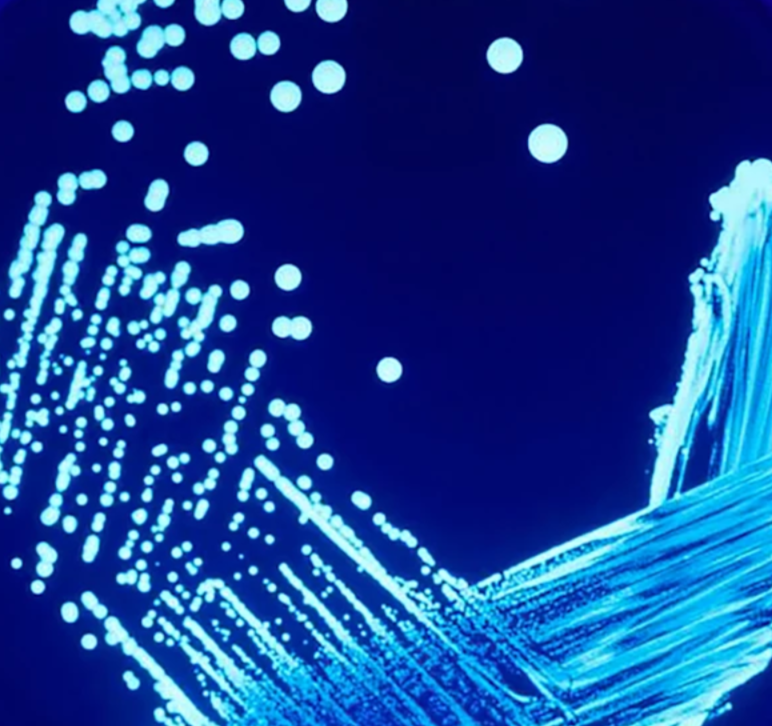
Legionella Management

Comprehensive Drinking and Utility Water Testing, Legionella Risk Management, and Quality Compliance Solutions for every facility and application.
Trusted by federal agencies, healthcare facilities, and mission-critical environments
I-2-I Solutions is on a mission to Safeguard Health with Science-led Water Quality Solutions.
Our team of biologists, technicians, and program managers delivers precise, reliable testing and hands-on support so facility leaders can stay focused on their mission while we manage the complex details of water quality assurance. We bring the same disciplined standards and documentation practices we’ve used in federal environments to every facility we support.

We collect defensible samples and capture field data that helps explain results, temperature, disinfectant residual, pH, and other indicators that impact system performance and microbial risk.

We test for Legionella and other microbiological markers using best-available methods, including culture and qPCR. Results are delivered promptly based on data, not assumptions.

We support healthcare and clinical environments with testing, sampling, monitoring tailored to meet regulatory documentation and reporting that works for audits and reviews.

We help you to monitor, benchmark practices and ensure continuous improvement through data-driven decision making and long-term partnership.

Our disc system performance, we help coordinate protocol application, or repair work to keep your water programs moving forward.

When contamination occurs, we support response planning and remediation efforts, helping facilities meet protocols while minimizing disruption to operations.
Facility teams are balancing limited time, evolving requirements, and the challenge of finding reliable, compliant partners. That’s why I-2-I Solutions provides end-to-end project management, from sampling to monitoring and reporting so your staff can focus on mission priorities, while we keep your water quality program moving forward.
In federal settings, expectations are clear: follow the standard, document every step, and deliver results that hold up under review. We bring that same rigor to your building water systems while keeping communication clear, practical, and easy to act on.
What truly defines I-2-I Solutions, however, is how we work. Our team brings decades of facility management expertise, guided by a thoughtful, human-centered approach. We listen first, understand real-world challenges, and build water quality programs that work for people, not just buildings.
Effective Legionella risk management begins with water systems that are thoughtfully designed and properly operated and maintained to minimize contamination and limit conditions that allow Legionella to grow. Routine testing is essential to validate these controls and ensure water management programs are achieving their intended objectives.
Our team of microbiologist, technicians, and program managers supports facilities with sampling, testing, monitoring, and consultation to keep operations safe and compliant.
Our work supports mission-critical facilities where safe water and strong documentation aren’t optional, they’re essential.

Proactive monitoring and reporting support to help teams stay ahead of risk.

Routine testing support with clear interpretation & compliance-ready reporting.

Program support built for continuity, clarity, and consistent follow-through.
Let’s build a compliance-driven, sustainable water management plan together.
Schedule Your Consultation